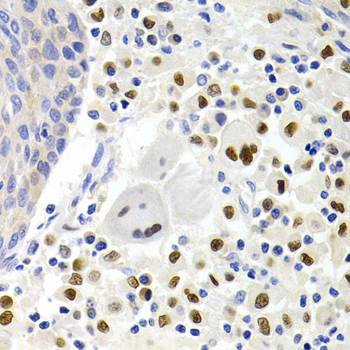

For quotations, please use our online quotation form, and you may also contact us by
service@kendallscientific.com
+1-888.733.6849 (Toll-free)
+1-617.299.7367 (Int’l))
+1-888.733.6849
Our customer service representatives are available 24 hours, Monday through Friday to assist you.| Reactivity | Human Mouse Rat |
| Tested applications | WB IHC IF |
| Recommended Dilution | WB 1:500 - 1:1000 IHC 1:50 - 1:200 IF 1:50 - 1:200 |
| Calculated MW | 32kDa |
| Observed MW | Refer to Figures |
| Immunogen | A synthetic peptide of human GEMIN2 |
| Storage Buffer | Store at -20℃. Avoid freeze / thaw cycles. Buffer: PBS with 0.02% sodium azide, 50% glycerol, pH7.3. |
| Synonym | SIP1; SIP1-delta |

Western blot analysis of extracts of Jurkat cell line, using GEMIN2 antibody.

Immunohistochemistry of paraffin-embedded human ovarian cancer tissue using GEMIN2 antibody.

Immunohistochemistry of paraffin-embedded rat liver using GEMIN2 antibody at dilution of 1:200 (400x lens).

Immunohistochemistry of paraffin-embedded human metrocarcinoma using GEMIN2 antibody at dilution of 1:200 (400x lens).

Immunohistochemistry of paraffin-embedded mouse lymph gland using GEMIN2 antibody at dilution of 1:200 (400x lens).
Immunohistochemistry of paraffin-embedded human lung cancer using GEMIN2 antibody at dilution of 1:200 (400x lens).

Immunohistochemistry of paraffin-embedded human appendicitis using GEMIN2 antibody at dilution of 1:200 (400x lens).

Immunofluorescence analysis of A549 cell using GEMIN2 antibody. Blue: DAPI for nuclear staining.
This gene encodes one of the proteins found in the SMN complex, which consists of several gemin proteins and the protein known as the survival of motor neuron protein. The SMN complex is localized to a subnuclear compartment called gems (gemini of coiled bodies) and is required for assembly of spliceosomal snRNPs and for pre-mRNA splicing. This protein interacts directly with the survival of motor neuron protein and it is required for formation of the SMN complex. A knockout mouse targeting the mouse homolog of this gene exhibited disrupted snRNP assembly and motor neuron degeneration.
N/A